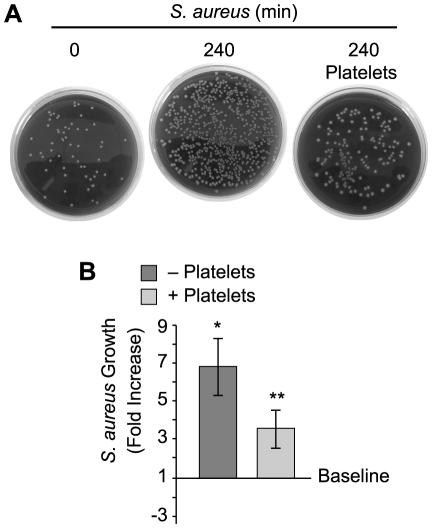
https://cdn.ncbi.nlm.nih.gov/pmc/blobs/9f45/3213094/848ad7a29ba5/ppat.1002355.g002.jpg

β-防御素 1 对人血小板的新型抗菌作用:抑制病原体生长和中性粒细胞胞外诱捕网形成的信号转导。
Novel anti-bacterial activities of β-defensin 1 in human platelets: suppression of pathogen growth and signaling of neutrophil extracellular trap formation.
机构信息
Molecular Medicine Program, University of Utah, Salt Lake City, Utah, United States of America.
出版信息
PLoS Pathog. 2011 Nov;7(11):e1002355. doi: 10.1371/journal.ppat.1002355. Epub 2011 Nov 10.
Human β-defensins (hBD) are antimicrobial peptides that curb microbial activity. Although hBD's are primarily expressed by epithelial cells, we show that human platelets express hBD-1 that has both predicted and novel antibacterial activities. We observed that activated platelets surround Staphylococcus aureus (S. aureus), forcing the pathogens into clusters that have a reduced growth rate compared to S. aureus alone. Given the microbicidal activity of β-defensins, we determined whether hBD family members were present in platelets and found mRNA and protein for hBD-1. We also established that hBD-1 protein resided in extragranular cytoplasmic compartments of platelets. Consistent with this localization pattern, agonists that elicit granular secretion by platelets did not readily induce hBD-1 release. Nevertheless, platelets released hBD-1 when they were stimulated by α-toxin, a S. aureus product that permeabilizes target cells. Platelet-derived hBD-1 significantly impaired the growth of clinical strains of S. aureus. hBD-1 also induced robust neutrophil extracellular trap (NET) formation by target polymorphonuclear leukocytes (PMNs), which is a novel antimicrobial function of β-defensins that was not previously identified. Taken together, these data demonstrate that hBD-1 is a previously-unrecognized component of platelets that displays classic antimicrobial activity and, in addition, signals PMNs to extrude DNA lattices that capture and kill bacteria.
人β-防御素(hBD)是抑制微生物活性的抗菌肽。虽然 hBD 主要由上皮细胞表达,但我们发现人血小板表达 hBD-1,具有预测和新的抗菌活性。我们观察到激活的血小板包围金黄色葡萄球菌(S. aureus),迫使病原体形成簇,与单独的 S. aureus 相比,其生长速度降低。鉴于β-防御素的杀菌活性,我们确定血小板中是否存在 hBD 家族成员,并发现 hBD-1 的 mRNA 和蛋白。我们还确定 hBD-1 蛋白存在于血小板的细胞外颗粒质区室中。与这种定位模式一致,通过血小板引发颗粒分泌的激动剂不易诱导 hBD-1 释放。然而,当血小板被α-毒素刺激时,它们会释放 hBD-1,α-毒素是一种可通透靶细胞的金黄色葡萄球菌产物。血小板衍生的 hBD-1 显著抑制了临床金黄色葡萄球菌菌株的生长。hBD-1 还诱导靶多形核白细胞(PMN)产生强烈的中性粒细胞胞外陷阱(NET)形成,这是β-防御素的一种新的抗菌功能,以前未被识别。总之,这些数据表明 hBD-1 是血小板中以前未被识别的成分,具有经典的抗菌活性,并且还可以指示 PMN 排出捕获和杀死细菌的 DNA 格子。